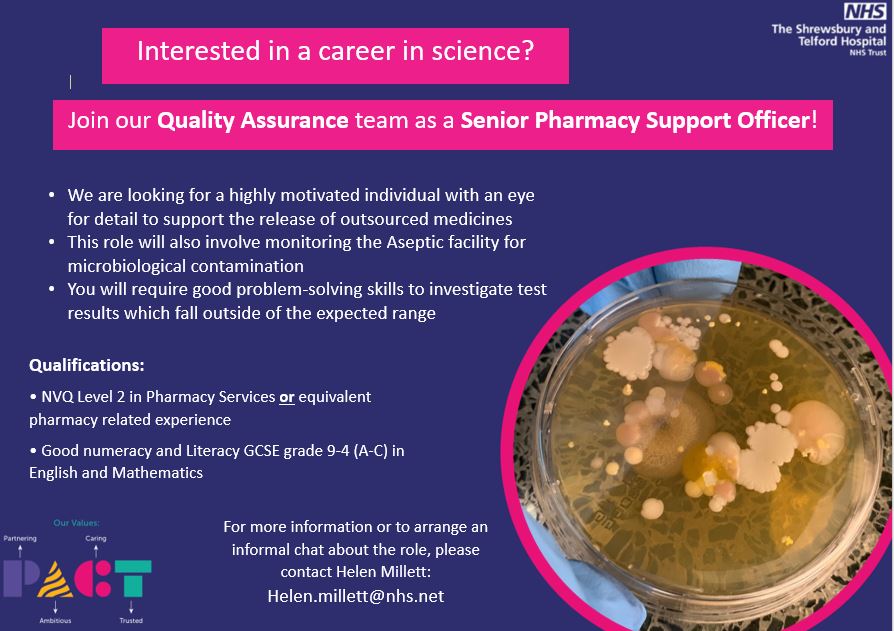
SaTH Pharmacy tweet media

Mandy Taylor retweetledi

Joanne talking about her research on health literacy. It’s really important to check our patients have understood the information we give them @sathNHS @TherapyServSath #improvement

English
Mandy Taylor
1.5K posts

















A wonderful session with our therapy colleagues today looking at the future of therapy services and how we can ensure the patient is at the heart of what we do with the changing needs of the population! It’s been a pleasure 🥰 thanks for having me #FuturePossibilities